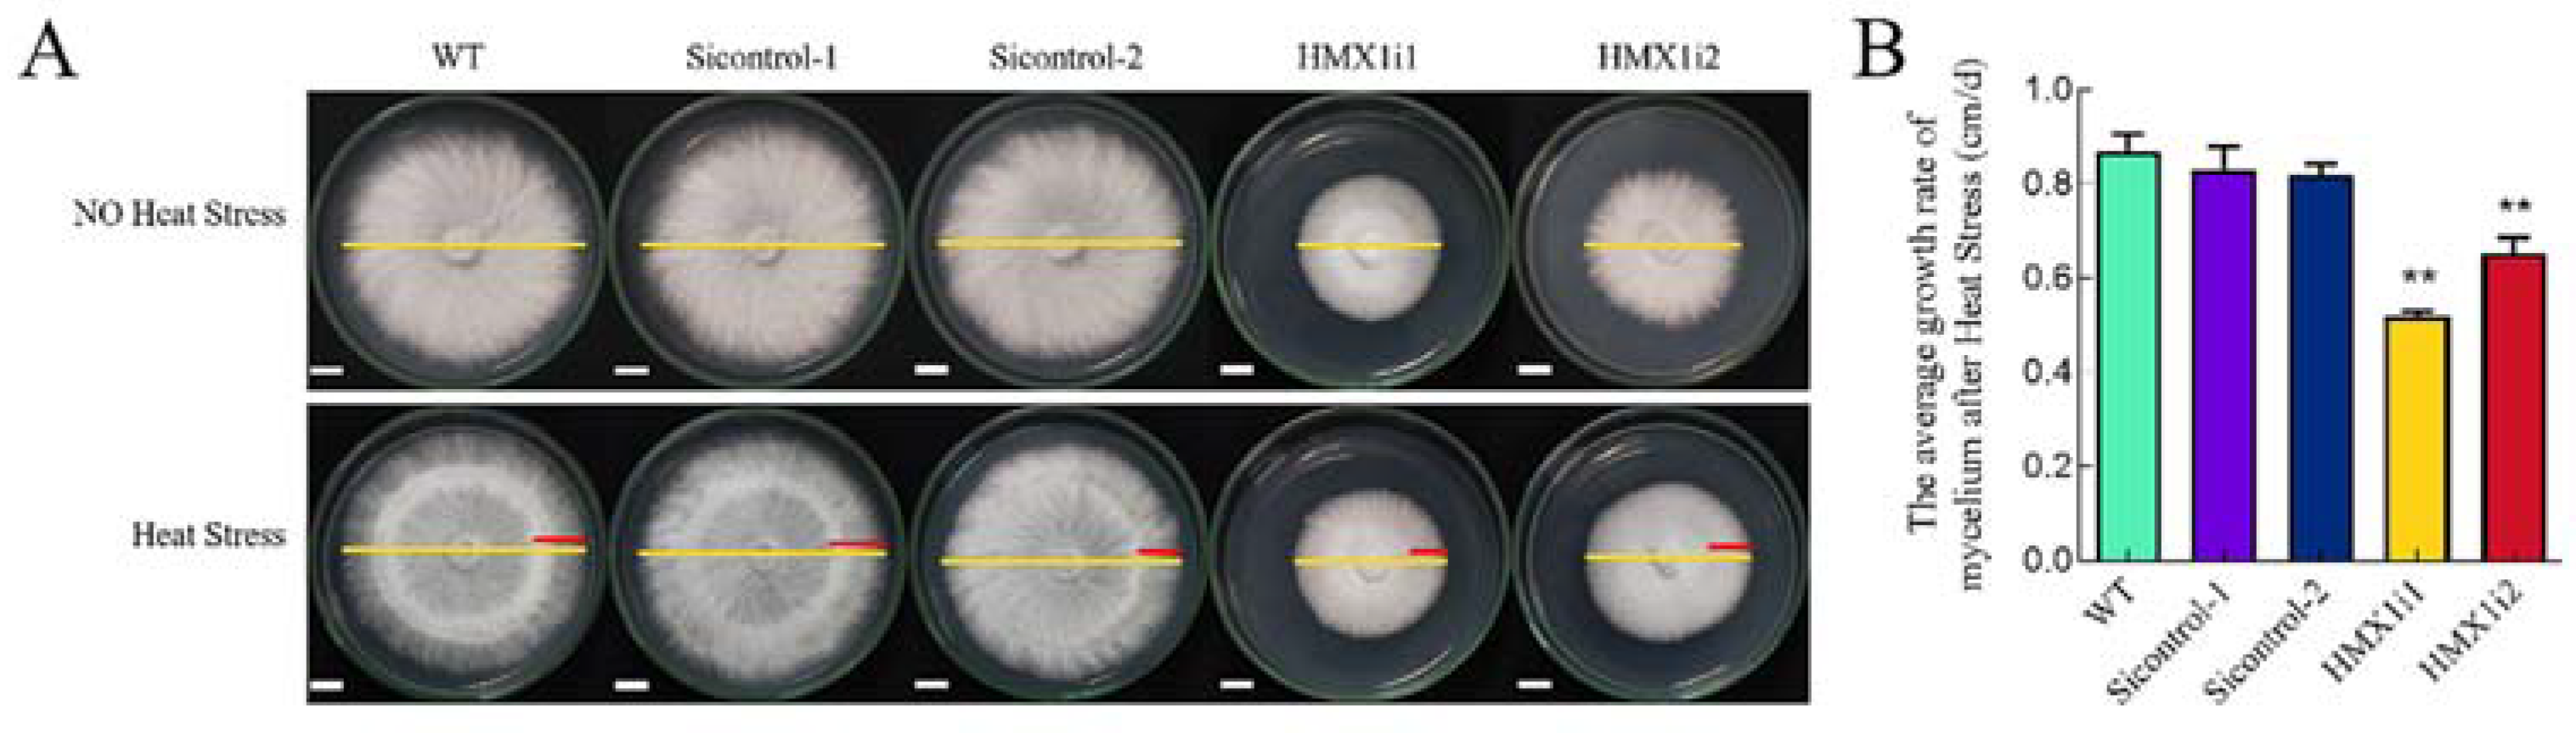
Ijms 23 13147 g002 Ijms 23 13147 g002

Heme Oxygenase/Carbon Monoxide Participates in the Regulation of Ganoderma lucidum Heat-Stress Response, Ganoderic Acid Biosynthesis, and Cell-Wall Integrity
Abstract
1. Introduction
2. Results
2.1. HMX1 Transcription Level, HO Enzyme Activity, and CO Content Were Increased under Heat Shock
2.2. Silencing of HMX1 Reduces the Ability of Mycelium to Restore Growth under Heat Shock
2.3. HO Affected GA Content under Heat Shock
2.4. CO and Bilirubin Affected the Biosynthesis of GA under Heat Shock
2.5. Silencing of HMX1 Affected the slt2 MAPK and Cell Wall
3. Discussion
4. Materials and Methods
4.1. Strains and Culture Conditions
4.2. Treatment of Mycelium
4.3. Quantitative Real-Time PCR (qRT-PCR)
4.4. Detection of Enzyme Activity
4.5. Detection of CO Content
4.6. Detection of GA Content (HPLC)
4.7. Determination of Mycelial Growth Rate and Cell Wall Stress Treatment
4.8. Detection of β-1,3-D-Glucan and Chitin in the Cell Wall
4.9. Western Blot
4.10. Statistical Analysis
5. Conclusions
Supplementary Materials
Author Contributions
Funding
Institutional Review Board Statement
Informed Consent Statement
Data Availability Statement
Conflicts of Interest
References
- Kawahara, B.; Gao, L.; Cohn, W.; Whitelegge, J.P.; Sen, S.; Janzen, C.; Mascharak, P.K. Diminished viability of human ovarian cancer cells by antigen-specific delivery of carbon monoxide with a family of photoactivatable antibody-photoCORM conjugates. Chem. Sci. 2020, 11, 467–473. [Google Scholar] [CrossRef] [PubMed]
- Wallace, J.L.; Ianaro, A.; Flannigan, K.L.; Cirino, G. Gaseous mediators in resolution of inflammation. Semin. Immunol. 2015, 27, 227–233. [Google Scholar] [CrossRef] [PubMed]
- Kolluru, G.K.; Shen, X.; Yuan, S.; Kevil, C.G. Gasotransmitter Heterocellular Signaling. Antioxid Redox Signal. 2017, 26, 936–960. [Google Scholar] [CrossRef] [PubMed]
- Figueiredo-Pereira, C.; Dias-Pedroso, D.; Soares, N.L.; Vieira, H.L.A. CO-mediated cytoprotection is dependent on cell metabolism modulation. Redox Biol. 2020, 32, 101470. [Google Scholar] [CrossRef]
- Chen, Y.; Wang, M.; Hu, L.; Liao, W.; Dawuda, M.M.; Li, C. Carbon Monoxide Is Involved in Hydrogen Gas-Induced Adventitious Root Development in Cucumber under Simulated Drought Stress. Front. Plant Sci. 2017, 8, 128. [Google Scholar] [CrossRef]
- Xie, Y.; Ling, T.; Han, Y.; Liu, K.; Zheng, Q.; Huang, L.; Yuan, X.; He, Z.; Hu, B.; Fang, L.; et al. Carbon monoxide enhances salt tolerance by nitric oxide-mediated maintenance of ion homeostasis and up-regulation of antioxidant defence in wheat seedling roots. Plant Cell Environ. 2008, 31, 1864–1881. [Google Scholar] [CrossRef]
- Wang, M.; Liao, W. Carbon Monoxide as a Signaling Molecule in Plants. Front. Plant Sci. 2016, 7, 572. [Google Scholar] [CrossRef]
- Ryter, S.W.; Otterbein, L.E.; Morse, D.; Choi, A.M. Heme oxygenase/carbon monoxide signaling pathways: Regulation and functional significance. Mol. Cell. Biochem. 2002, 234–235, 249–263. [Google Scholar] [CrossRef]
- Cui, W.; Li, L.; Gao, Z.; Wu, H.; Xie, Y.; Shen, W. Haem oxygenase-1 is involved in salicylic acid-induced alleviation of oxidative stress due to cadmium stress in Medicago sativa. J. Exp. Bot. 2012, 63, 5521–5534. [Google Scholar] [CrossRef]
- Cao, Z.; Geng, B.; Xu, S.; Xuan, W.; Nie, L.; Shen, W.; Liang, Y.; Guan, R. BnHO1, a haem oxygenase-1 gene from Brassica napus, is required for salinity and osmotic stress-induced lateral root formation. J. Exp. Bot. 2011, 62, 4675–4689. [Google Scholar] [CrossRef]
- Ding, P.; Fang, L.; Wang, G.; Li, X.; Huang, S.; Gao, Y.; Zhu, J.; Xiao, L.; Tong, J.; Chen, F.; et al. Wheat methionine sulfoxide reductase A4.1 interacts with heme oxygenase 1 to enhance seedling tolerance to salinity or drought stress. Plant Mol. Biol. 2019, 101, 203–220. [Google Scholar] [CrossRef] [PubMed]
- de Souza, A.F.; Tomazett, M.V.; Freitas, E.S.K.S.; de Curcio, J.S.; Pereira, C.A.; Baeza, L.C.; Paccez, J.D.; Gonçales, R.A.; Rodrigues, F.; Pereira, M.; et al. Interacting with Hemoglobin: Paracoccidioides spp. Recruits hsp30 on Its Cell Surface for Enhanced Ability to Use This Iron Source. J. Fungi 2021, 7, 21. [Google Scholar] [CrossRef] [PubMed]
- Streng, C.; Hartmann, J.; Leister, K.; Krauß, N.; Lamparter, T.; Frankenberg-Dinkel, N.; Weth, F.; Bastmeyer, M.; Yu, Z.; Fischer, R. Fungal phytochrome chromophore biosynthesis at mitochondria. EMBO J. 2021, 40, e108083. [Google Scholar] [CrossRef] [PubMed]
- El Enshasy, H.A.; Hatti-Kaul, R. Mushroom immunomodulators: Unique molecules with unlimited applications. Trends Biotechnol. 2013, 31, 668–677. [Google Scholar] [CrossRef]
- Chen, D.D.; Shi, L.; Yue, S.N.; Zhang, T.J.; Wang, S.L.; Liu, Y.N.; Ren, A.; Zhu, J.; Yu, H.S.; Zhao, M.W. The Slt2-MAPK pathway is involved in the mechanism by which target of rapamycin regulates cell wall components in Ganoderma lucidum. Fungal Genet. Biol. 2019, 123, 70–77. [Google Scholar] [CrossRef]
- Su, H.G.; Peng, X.R.; Shi, Q.Q.; Huang, Y.J.; Zhou, L.; Qiu, M.H. Lanostane triterpenoids with anti-inflammatory activities from Ganoderma lucidum. Phytochemistry 2020, 173, 112256. [Google Scholar] [CrossRef]
- Chang, C.J.; Lin, C.S.; Lu, C.C.; Martel, J.; Ko, Y.F.; Ojcius, D.M.; Tseng, S.F.; Wu, T.R.; Chen, Y.Y.; Young, J.D.; et al. Ganoderma lucidum reduces obesity in mice by modulating the composition of the gut microbiota. Nat. Commun. 2015, 6, 7489. [Google Scholar] [CrossRef]
- Guo, C.; Guo, D.; Fang, L.; Sang, T.; Wu, J.; Guo, C.; Wang, Y.; Wang, Y.; Chen, C.; Chen, J.; et al. Ganoderma lucidum polysaccharide modulates gut microbiota and immune cell function to inhibit inflammation and tumorigenesis in colon. Carbohydr. Polym. 2021, 267, 118231. [Google Scholar] [CrossRef]
- Zhang, X.; Ren, A.; Li, M.J.; Cao, P.F.; Chen, T.X.; Zhang, G.; Shi, L.; Jiang, A.L.; Zhao, M.W. Heat Stress Modulates Mycelium Growth, Heat Shock Protein Expression, Ganoderic Acid Biosynthesis, and Hyphal Branching of Ganoderma lucidum via Cytosolic Ca2. Appl. Environ. Microbiol. 2016, 82, 4112–4125. [Google Scholar] [CrossRef]
- Cao, P.F.; Wu, C.G.; Dang, Z.H.; Shi, L.; Jiang, A.L.; Ren, A.; Zhao, M.W. Effects of Exogenous Salicylic Acid on Ganoderic Acid Biosynthesis and the Expression of Key Genes in the Ganoderic Acid Biosynthesis Pathway in the Lingzhi or Reishi Medicinal Mushroom, Ganoderma lucidum (Agaricomycetes). Int. J. Med. Mushrooms 2017, 19, 65–73. [Google Scholar] [CrossRef]
- Ren, A.; Qin, L.; Shi, L.; Dong, X.; Mu da, S.; Li, Y.X.; Zhao, M.W. Methyl jasmonate induces ganoderic acid biosynthesis in the basidiomycetous fungus Ganoderma lucidum. Bioresour. Technol. 2010, 101, 6785–6790. [Google Scholar] [CrossRef] [PubMed]
- Lu, X.; Xie, C.; Wang, Y.; Liu, Y.; Han, J.; Shi, L.; Zhu, J.; Yu, H.; Ren, A.; Zhao, M. Function of ceramide synthases on growth, ganoderic acid biosynthesis and sphingolipid homeostasis in Ganoderma lucidum. Phytochemistry 2020, 172, 112283. [Google Scholar] [CrossRef] [PubMed]
- Liu, R.; Zhang, X.; Ren, A.; Shi, D.K.; Shi, L.; Zhu, J.; Yu, H.S.; Zhao, M.W. Heat stress-induced reactive oxygen species participate in the regulation of HSP expression, hyphal branching and ganoderic acid biosynthesis in Ganoderma lucidum. Microbiol. Res. 2018, 209, 43–54. [Google Scholar] [CrossRef] [PubMed]
- Wang, T.; Wang, Y.; Chen, C.; Ren, A.; Yu, H.; Zhao, M. Effect of the heme oxygenase gene on mycelial growth and polysaccharide synthesis in Ganoderma lucidum. J. Basic Microbiol. 2021, 61, 253–264. [Google Scholar] [CrossRef]
- Zhang, G.; Ren, A.; Wu, F.; Yu, H.; Shi, L.; Zhao, M. Ethylene promotes mycelial growth and ganoderic acid biosynthesis in Ganoderma lucidum. Biotechnol. Lett. 2017, 39, 269–275. [Google Scholar] [CrossRef]
- You, B.J.; Lee, M.H.; Tien, N.; Lee, M.S.; Hsieh, H.C.; Tseng, L.H.; Chung, Y.L.; Lee, H.Z. A novel approach to enhancing ganoderic acid production by Ganoderma lucidum using apoptosis induction. PLoS ONE 2013, 8, e53616. [Google Scholar] [CrossRef]
- Ren, A.; Li, X.B.; Miao, Z.G.; Shi, L.; Jaing, A.L.; Zhao, M.W. Transcript and metabolite alterations increase ganoderic acid content in Ganoderma lucidum using acetic acid as an inducer. Biotechnol. Lett. 2014, 36, 2529–2536. [Google Scholar] [CrossRef]
- Zhao, W.; Xu, J.W.; Zhong, J.J. Enhanced production of ganoderic acids in static liquid culture of Ganoderma lucidum under nitrogen-limiting conditions. Bioresour. Technol. 2011, 102, 8185–8190. [Google Scholar] [CrossRef]
- Liu, Y.N.; Lu, X.X.; Chen, D.; Lu, Y.P.; Ren, A.; Shi, L.; Zhu, J.; Jiang, A.L.; Yu, H.S.; Zhao, M.W. Phospholipase D and phosphatidic acid mediate heat stress induced secondary metabolism in Ganoderma lucidum. Environ. Microbiol. 2017, 19, 4657–4669. [Google Scholar] [CrossRef]
- Abdalla, M.Y.; Ahmad, I.M.; Switzer, B.; Britigan, B.E. Induction of heme oxygenase-1 contributes to survival of Mycobacterium abscessus in human macrophages-like THP-1 cells. Redox Biol. 2015, 4, 328–339. [Google Scholar] [CrossRef][Green Version]
- Otterbein, L.E.; Bach, F.H.; Alam, J.; Soares, M.; Tao Lu, H.; Wysk, M.; Davis, R.J.; Flavell, R.A.; Choi, A.M. Carbon monoxide has anti-inflammatory effects involving the mitogen-activated protein kinase pathway. Nat. Med. 2000, 6, 422–428. [Google Scholar] [CrossRef] [PubMed]
- Kohmoto, J.; Nakao, A.; Stolz, D.B.; Kaizu, T.; Tsung, A.; Ikeda, A.; Shimizu, H.; Takahashi, T.; Tomiyama, K.; Sugimoto, R.; et al. Carbon monoxide protects rat lung transplants from ischemia-reperfusion injury via a mechanism involving p38 MAPK pathway. Am. J. Transplant. 2007, 7, 2279–2290. [Google Scholar] [CrossRef] [PubMed]
- Leskoske, K.L.; Roelants, F.M.; Emmerstorfer-Augustin, A.; Augustin, C.M.; Si, E.P.; Hill, J.M.; Thorner, J. Phosphorylation by the stress-activated MAPK Slt2 down-regulates the yeast TOR complex 2. Genes Dev. 2018, 32, 1576–1590. [Google Scholar] [CrossRef] [PubMed]
- Zhang, G.; Sun, Z.; Ren, A.; Shi, L.; Shi, D.; Li, X.; Zhao, M. The mitogen-activated protein kinase GlSlt2 regulates fungal growth, fruiting body development, cell wall integrity, oxidative stress and ganoderic acid biosynthesis in Ganoderma lucidum. Fungal Genet. Biol. 2017, 104, 6–15. [Google Scholar] [CrossRef] [PubMed]
- Ryter, S.W. Therapeutic Potential of Heme Oxygenase-1 and Carbon Monoxide in Acute Organ Injury, Critical Illness, and Inflammatory Disorders. Antioxidants 2020, 9, 1153. [Google Scholar] [CrossRef]
- Ryter, S.W.; Otterbein, L.E. Carbon monoxide in biology and medicine. Bioessays 2004, 26, 270–280. [Google Scholar] [CrossRef] [PubMed]
- Shekhawat, G.S.; Verma, K. Haem oxygenase (HO): An overlooked enzyme of plant metabolism and defence. J. Exp. Bot. 2010, 61, 2255–2270. [Google Scholar] [CrossRef] [PubMed]
- Campbell, N.K.; Fitzgerald, H.K.; Dunne, A. Regulation of inflammation by the antioxidant haem oxygenase 1. Nat. Rev. Immunol. 2021, 21, 411–425. [Google Scholar] [CrossRef] [PubMed]
- Stucki, D.; Steinhausen, J.; Westhoff, P.; Krahl, H.; Brilhaus, D.; Massenberg, A.; Weber, A.P.M.; Reichert, A.S.; Brenneisen, P.; Stahl, W. Endogenous Carbon Monoxide Signaling Modulates Mitochondrial Function and Intracellular Glucose Utilization: Impact of the Heme Oxygenase Substrate Hemin. Antioxidants 2020, 9, 652. [Google Scholar] [CrossRef] [PubMed]
- Feng, J.; Feng, N.; Zhang, J.S.; Yang, Y.; Jia, W.; Lin, C.C. A New Temperature Control Shifting Strategy for Enhanced Triterpene Production by Ganoderma lucidum G0119 Based on Submerged Liquid Fermentation. Appl. Biochem. Biotechnol. 2016, 180, 740–752. [Google Scholar] [CrossRef] [PubMed]
- Liu, Y.N.; Zhang, T.J.; Lu, X.X.; Ma, B.L.; Ren, A.; Shi, L.; Jiang, A.L.; Yu, H.S.; Zhao, M.W. Membrane fluidity is involved in the regulation of heat stress induced secondary metabolism in Ganoderma lucidum. Environ. Microbiol. 2017, 19, 1653–1668. [Google Scholar] [CrossRef]
- Cui, M.; Ma, Y.; Yu, Y. Heme oxygenase-1/carbon monoxide signaling participates in the accumulation of triterpenoids of Ganoderma lucidum. J. Zhejiang Univ. Sci. B 2021, 22, 941–953. [Google Scholar] [CrossRef] [PubMed]
- Yao, H.; Peterson, A.L.; Li, J.; Xu, H.; Dennery, P.A. Heme Oxygenase 1 and 2 Differentially Regulate Glucose Metabolism and Adipose Tissue Mitochondrial Respiration: Implications for Metabolic Dysregulation. Int. J. Mol. Sci. 2020, 21, 7123. [Google Scholar] [CrossRef] [PubMed]
- Kim, H.P.; Ryter, S.W.; Choi, A.M. CO as a cellular signaling molecule. Annu. Rev. Pharmacol. Toxicol. 2006, 46, 411–449. [Google Scholar] [CrossRef] [PubMed]
- Livak, K.J.; Schmittgen, T.D. Analysis of relative gene expression data using real-time quantitative PCR and the 2(-Delta Delta C(T)) Method. Methods 2001, 25, 402–408. [Google Scholar] [CrossRef] [PubMed]
- Xuan, W.; Zhu, F.Y.; Xu, S.; Huang, B.K.; Ling, T.F.; Qi, J.Y.; Ye, M.B.; Shen, W.B. The heme oxygenase/carbon monoxide system is involved in the auxin-induced cucumber adventitious rooting process. Plant Physiol. 2008, 148, 881–893. [Google Scholar] [CrossRef] [PubMed]
- Lin, J.S.; Lin, H.H.; Li, Y.C.; King, Y.C.; Sung, R.J.; Kuo, Y.W.; Lin, C.C.; Shen, Y.H.; Jeng, S.T. Carbon monoxide regulates the expression of the wound-inducible gene ipomoelin through antioxidation and MAPK phosphorylation in sweet potato. J. Exp. Bot. 2014, 65, 5279–5290. [Google Scholar] [CrossRef] [PubMed]
- Kong, W.W.; Zhang, L.P.; Guo, K.; Liu, Z.P.; Yang, Z.M. Carbon monoxide improves adaptation of Arabidopsis to iron deficiency. Plant Biotechnol. J. 2010, 8, 88–99. [Google Scholar] [CrossRef] [PubMed]
- Shi, L.; Gong, L.; Zhang, X.; Ren, A.; Gao, T.; Zhao, M. The regulation of methyl jasmonate on hyphal branching and GA biosynthesis in Ganoderma lucidum partly via ROS generated by NADPH oxidase. Fungal Genet. Biol. 2015, 81, 201–211. [Google Scholar] [CrossRef]
- Fortwendel, J.R.; Juvvadi, P.R.; Pinchai, N.; Perfect, B.Z.; Alspaugh, J.A.; Perfect, J.R.; Steinbach, W.J. Differential effects of inhibiting chitin and 1,3-{beta}-D-glucan synthesis in ras and calcineurin mutants of Aspergillus fumigatus. Antimicrob. Agents Chemother. 2009, 53, 476–482. [Google Scholar] [CrossRef]
- Li, M.; Chen, T.; Gao, T.; Miao, Z.; Jiang, A.; Shi, L.; Ren, A.; Zhao, M. UDP-glucose pyrophosphorylase influences polysaccharide synthesis, cell wall components, and hyphal branching in Ganoderma lucidum via regulation of the balance between glucose-1-phosphate and UDP-glucose. Fungal Genet. Biol. 2015, 82, 251–263. [Google Scholar] [CrossRef] [PubMed]

Publisher’s Note: MDPI stays neutral with regard to jurisdictional claims in published maps and institutional affiliations. |
© 2022 by the authors. Licensee MDPI, Basel, Switzerland. This article is an open access article distributed under the terms and conditions of the Creative Commons Attribution (CC BY) license (https://creativecommons.org/licenses/by/4.0/).
Share and Cite
Wu, T.; Liu, X.; Wang, T.; Tian, L.; Qiu, H.; Ge, F.; Zhu, J.; Shi, L.; Jiang, A.; Yu, H.; et al. Heme Oxygenase/Carbon Monoxide Participates in the Regulation of Ganoderma lucidum Heat-Stress Response, Ganoderic Acid Biosynthesis, and Cell-Wall Integrity. Int. J. Mol. Sci. 2022, 23, 13147. https://doi.org/10.3390/ijms232113147
Wu T, Liu X, Wang T, Tian L, Qiu H, Ge F, Zhu J, Shi L, Jiang A, Yu H, et al. Heme Oxygenase/Carbon Monoxide Participates in the Regulation of Ganoderma lucidum Heat-Stress Response, Ganoderic Acid Biosynthesis, and Cell-Wall Integrity. International Journal of Molecular Sciences. 2022; 23(21):13147. https://doi.org/10.3390/ijms232113147
Chicago/Turabian StyleWu, Tao, Xiaotian Liu, Ting Wang, Li Tian, Hao Qiu, Feng Ge, Jing Zhu, Liang Shi, Ailiang Jiang, Hanshou Yu, and et al. 2022. "Heme Oxygenase/Carbon Monoxide Participates in the Regulation of Ganoderma lucidum Heat-Stress Response, Ganoderic Acid Biosynthesis, and Cell-Wall Integrity" International Journal of Molecular Sciences 23, no. 21: 13147. https://doi.org/10.3390/ijms232113147
APA StyleWu, T., Liu, X., Wang, T., Tian, L., Qiu, H., Ge, F., Zhu, J., Shi, L., Jiang, A., Yu, H., & Ren, A. (2022). Heme Oxygenase/Carbon Monoxide Participates in the Regulation of Ganoderma lucidum Heat-Stress Response, Ganoderic Acid Biosynthesis, and Cell-Wall Integrity. International Journal of Molecular Sciences, 23(21), 13147. https://doi.org/10.3390/ijms232113147

